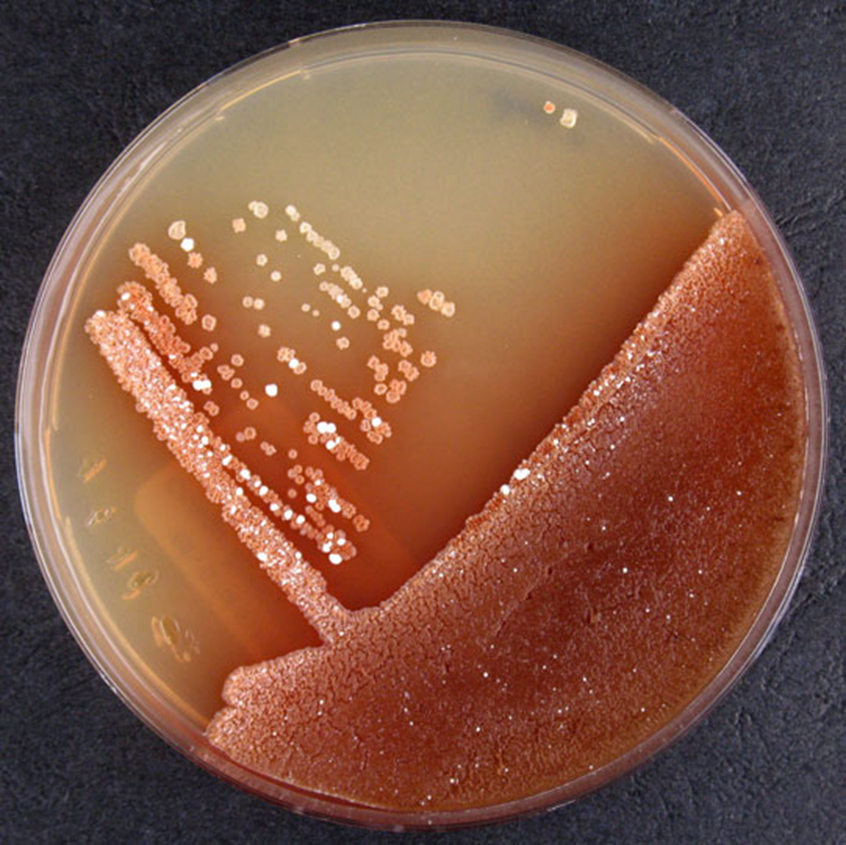

2025/1/29
こんにちは。兵庫県川西市議会議員の長田たくや(ながたく)です。
アメリカで赤色3号が禁止になったと話題になっています。

動物での発がん性が認められたというお話ですが、結構昔から使われていたので、なんだか政治的な動きもありそうです(リンク)。

結構詳しく説明してくれるサイトも多く、関心の高さがうかがえます。
(リンク:赤色3号とは何か)
重複して書くのもアレなので、私が気になるところピックアップしています。
■ 赤色3号はエリスロシン
ここ医療従事者はたぶん引っかかるのですが、エリスロシン®という薬(抗生物質)があります。私もはじめ、”えっ!?抗生物質なの?”と騙されました(笑)。

【なんで同じ名前なんや…】
ερυθρός(エリスロース)は「赤い、赤色の」の形容詞です。赤色3号は色から来ていますが、医薬品の方は発見元の放線菌Streptomyces erythraeusより命名されています。この菌が赤色素を出すようです。
■ タール系色素
元々コールタールより生成されていましたが、不純物が多く発がん性が懸念されたため、のちに石油由来で合成されるようになりました。
そもそもタールってなんや?
―――石炭を燃やして不純物を取り除き、炭素だけにしたものがコークスです。その際、得られる油状のものがタールになります。

なんとなく、フェナントレンからエリスロシンがつくれそうですね。ちなみに、燃やす工程を”乾留”といいます。空気に触れずに熱することですね。

■ 油からはナフサが取れる
石炭➡コールタールでしたが、石油➡ナフサという透明な液体が得られます。ナフサから様々な物質が作られており、合成色素もその1つ。

■ 赤色〇号
赤色には以下の号が存在します。それぞれ少しずつ異なりますね。なんで6号とか7号がないのかな?と調べたら、日本では使用禁止になったとか、認可されていないなどで4~39号が欠番になっています。

世界ではどのような認可状況なのか。ちょっと古いけど、このようなデータがありました。

添加物大国と言われてもおかしくないですね・・・
■ 日本も考えよう
合成着色料の摂取量は微量であり、害はないと言われていますが…そこまでして染めなくてもいいんじゃないかな?
天然色素となると価格も上昇するそうですが、特別な日のご飯として少々高くても良いと思います。ラズベリーソースとか、ちょっとした贅沢なアイスやステーキなどに使うので良くないか?普段の日は着色されていない食品を使い、ハレの日ケの日の考え方で生活習慣を変えても良いと思います。
防腐剤のような安全性に必須ではなく、着色料が禁止されている外国では特に不自由していないでしょう?これでは、病気にするために日本は規制が緩いと疑われても仕方がない。
味覚に対して色彩は非常に関係しており、黄色のボトルだと酸っぱさを強く感じることがわかっています。色素が味に強い影響を及ぼすことから、人の生活から離しにくいのも理解はできます。このあたりは諸外国のマネしても良いのではないでしょうか。

LGBTとかは率先して世界に迎合する日本ですが、ワクチン接種や合成着色料にはえらく”個性的な判断”です。
最後までお読みいただき、ありがとうございました。
素敵な1日でありますように。
ご意見・ご感想はこちらまで↓
takuya_nagata_1026@yahoo.co.jp
•━━━━━━• ∙ʚ🐤ɞ∙ •━━━━━━•
各種SNSもフォローを宜しくお願いします。
X(旧Twitter)
Facebook
インスタグラム
LINEオープンチャット(ニックネームで参加可能)
•━━━━━━• ∙ʚ🐤ɞ∙ •━━━━━━•
この記事をシェアする
ホーム>政党・政治家>長田 たくや (ナガタ タクヤ)>アメリカで赤色3号が禁止になった 【日本は使えるよ】